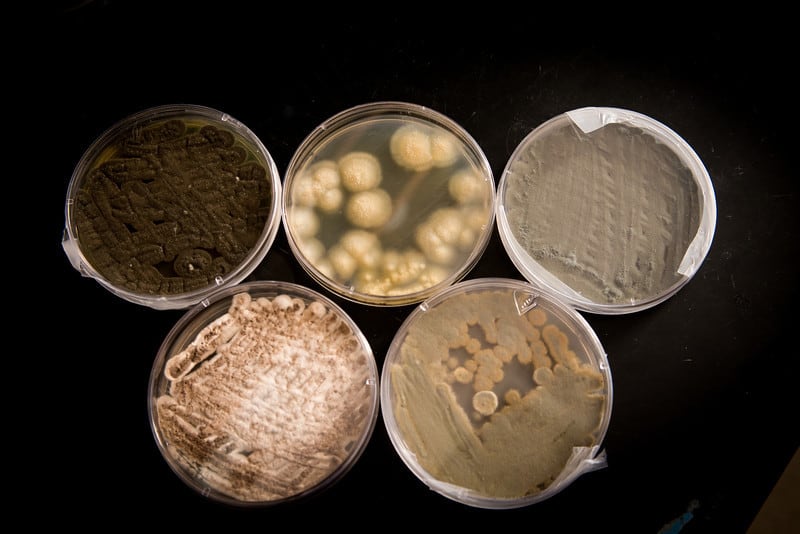

Kathleen Dannelly, associate professor of microbiology at Indiana State University (ISU) said she began researching the drink after an Indiana family found a fungal mat in a Capri Sun pouch.
Dannelly said: “The significance of this is that for the majority of people, other than being grossed out when you open a package and it has a large fungal mat – which is a really nasty looking thing – it will not hurt you.”
She added: “However, in patients who are immune-compromised and [have] some other underlying diseases, this could create a health concern for them.”
‘Not a common occurrence’
Kraft Foods was unavailable for comment as we went to press, but the firm admits mold does occur on an undated Capri Sun Q&A page. It says that, “while this is not a common occurrence”, it occasionally happened since the heat-treated, aseptically filled product is preservative free.
“That why we recommend discarding leaking or damaged packages and have included a statement on our cartons for consumers,” Kraft Foods (which manufactures Capri Sun in North America) adds.
A spokeswoman for the Switzerland headquartered Capri Sun brand referred us to Kraft Foods, but said the brand had had no consumer complaints in Germany relating to mold.
ISU senior biology major Leah Horn, who has spent the last year filtering Capri Sun through a vacuum and seeing if fungal microbes remained behind and grew on filter paper.
The university said that Horn found five fungi (pictured below): Three from the Tropical Punch flavor of the drink, one from Roarin’ Waters, and one from Fruit Punch variant, and was still testing to determine mold species.
Clear pouches created manufacturing problems
She will now test the theory that fungal mats grow in damaged packs, theorizing that a gas injected into the pouches removes oxygen, but that holes enable the gas to escape and mold to grow.
“We’re just going to puncture these Capri Sun packages and see if there are spores already in there, which we think is already the case, and see if we can get those mats to grow,” Horn said.
On its Capri Sun Q&A page, Kraft Foods tells consumers that a mold-related recall was unnecessary, since nothing indicated there was a broader problem and mold spores were found everywhere.
“Typically, mold must be inhaled to cause allergic symptoms. When mold is found in Capri Sun, it is immersed in liquid which would prevent the spores from becoming airborne and inhaled,” Kraft adds.
Clear pouches warning consumers as to the presence of mold would not a viable solution, Kraft said, since this involved it using two different manufacturing materials. A Roarin’ Waters trial upon this basis led to “manufacturing problems” and a return to a full-foil pouch, the firm adds.
Aseptic Technology 2013: Exclusive, free online event
On May 30, BeverageDaily.com and FoodProductionDaily.com will host an exclusive, free, online event on aseptic processing and packaging technology, Aseptic Technology 2013. Our program includes speakers from Sidel, GEA, Coca-Cola Hellenic, Zenith International and more. The event begins at 9am New York time. Click here to register and to learn more.